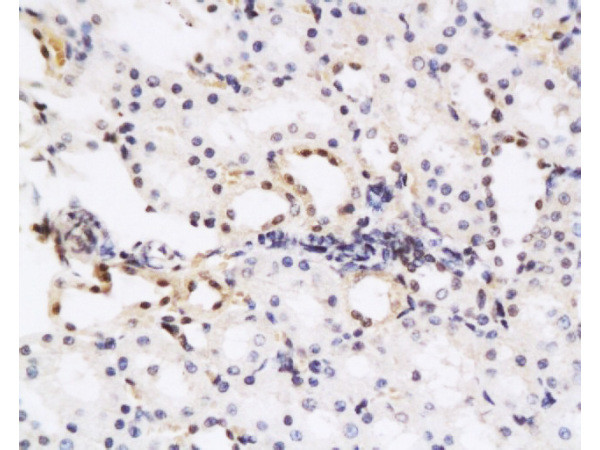
HGF Antibody in Immunohistochemistry (Paraffin) (IHC (P))

Search
Bioss
HGF Polyclonal Antibody
{{$productOrderCtrl.translations['antibody.pdp.commerceCard.promotion.promotions']}}
{{$productOrderCtrl.translations['antibody.pdp.commerceCard.promotion.viewpromo']}}
{{$productOrderCtrl.translations['antibody.pdp.commerceCard.promotion.promocode']}}: {{promo.promoCode}} {{promo.promoTitle}} {{promo.promoDescription}}. {{$productOrderCtrl.translations['antibody.pdp.commerceCard.promotion.learnmore']}}
产品信息
BS-1025R
种属反应
宿主/亚型
分类
类型
抗原
偶联物
形式
浓度
规格
纯化类型
保存液
内含物
保存条件
运输条件
靶标信息
Hepatocyte growth factor regulates cell growth, cell motility, and morphogenesis by activating a tyrosine kinase signaling cascade after binding to the proto-oncogenic c-Met receptor. Hepatocyte growth factor is secreted by mesenchymal cells and acts as a multi-functional cytokine on cells of mainly epithelial origin. Its ability to stimulate mitogenesis, cell motility, and matrix invasion gives it a central role in angiogenesis, tumorogenesis, and tissue regeneration. It is secreted as a single inactive polypeptide and is cleaved by serine proteases into a 69-kDa alpha-chain and 34-kDa beta-chain. A disulfide bond between the alpha and beta chains produces the active, heterodimeric molecule. The protein belongs to the plasminogen subfamily of S1 peptidases but has no detectable protease activity. Alternative splicing of this gene produces multiple transcript variants encoding different isoforms.
仅用于科研。不用于诊断过程。未经明确授权不得转售。
篇参考文献 (0)
生物信息学
蛋白别名: Fibroblast derived tumor cytotoxic factor; fibroblast-derived tumor cytotoxic factor; Hepatocyte growth factor; Hepatocyte growth factor (hepapoietin A; hepatocyte growth factor (hepapoietin A; scatter factor); Hepatopoeitin A; hepatopoeitin-A; Hepatopoietin-A; HepatopoietinA; HGF; Lung fibroblast derived mitogen; lung fibroblast-derived mitogen; Scatter factor; scatter factor); SF; unnamed protein product
基因别名: C230052L06Rik; DFNB39; F-TCF; HGF; HGF/SF; HGFB; HPTA; NK1; NK2; SF; SF/HGF
UniProt ID: (Human) P14210, (Mouse) Q08048, (Rat) P17945
Entrez Gene ID: (Human) 3082, (Sheep) 443075, (Mouse) 15234, (Rat) 24446